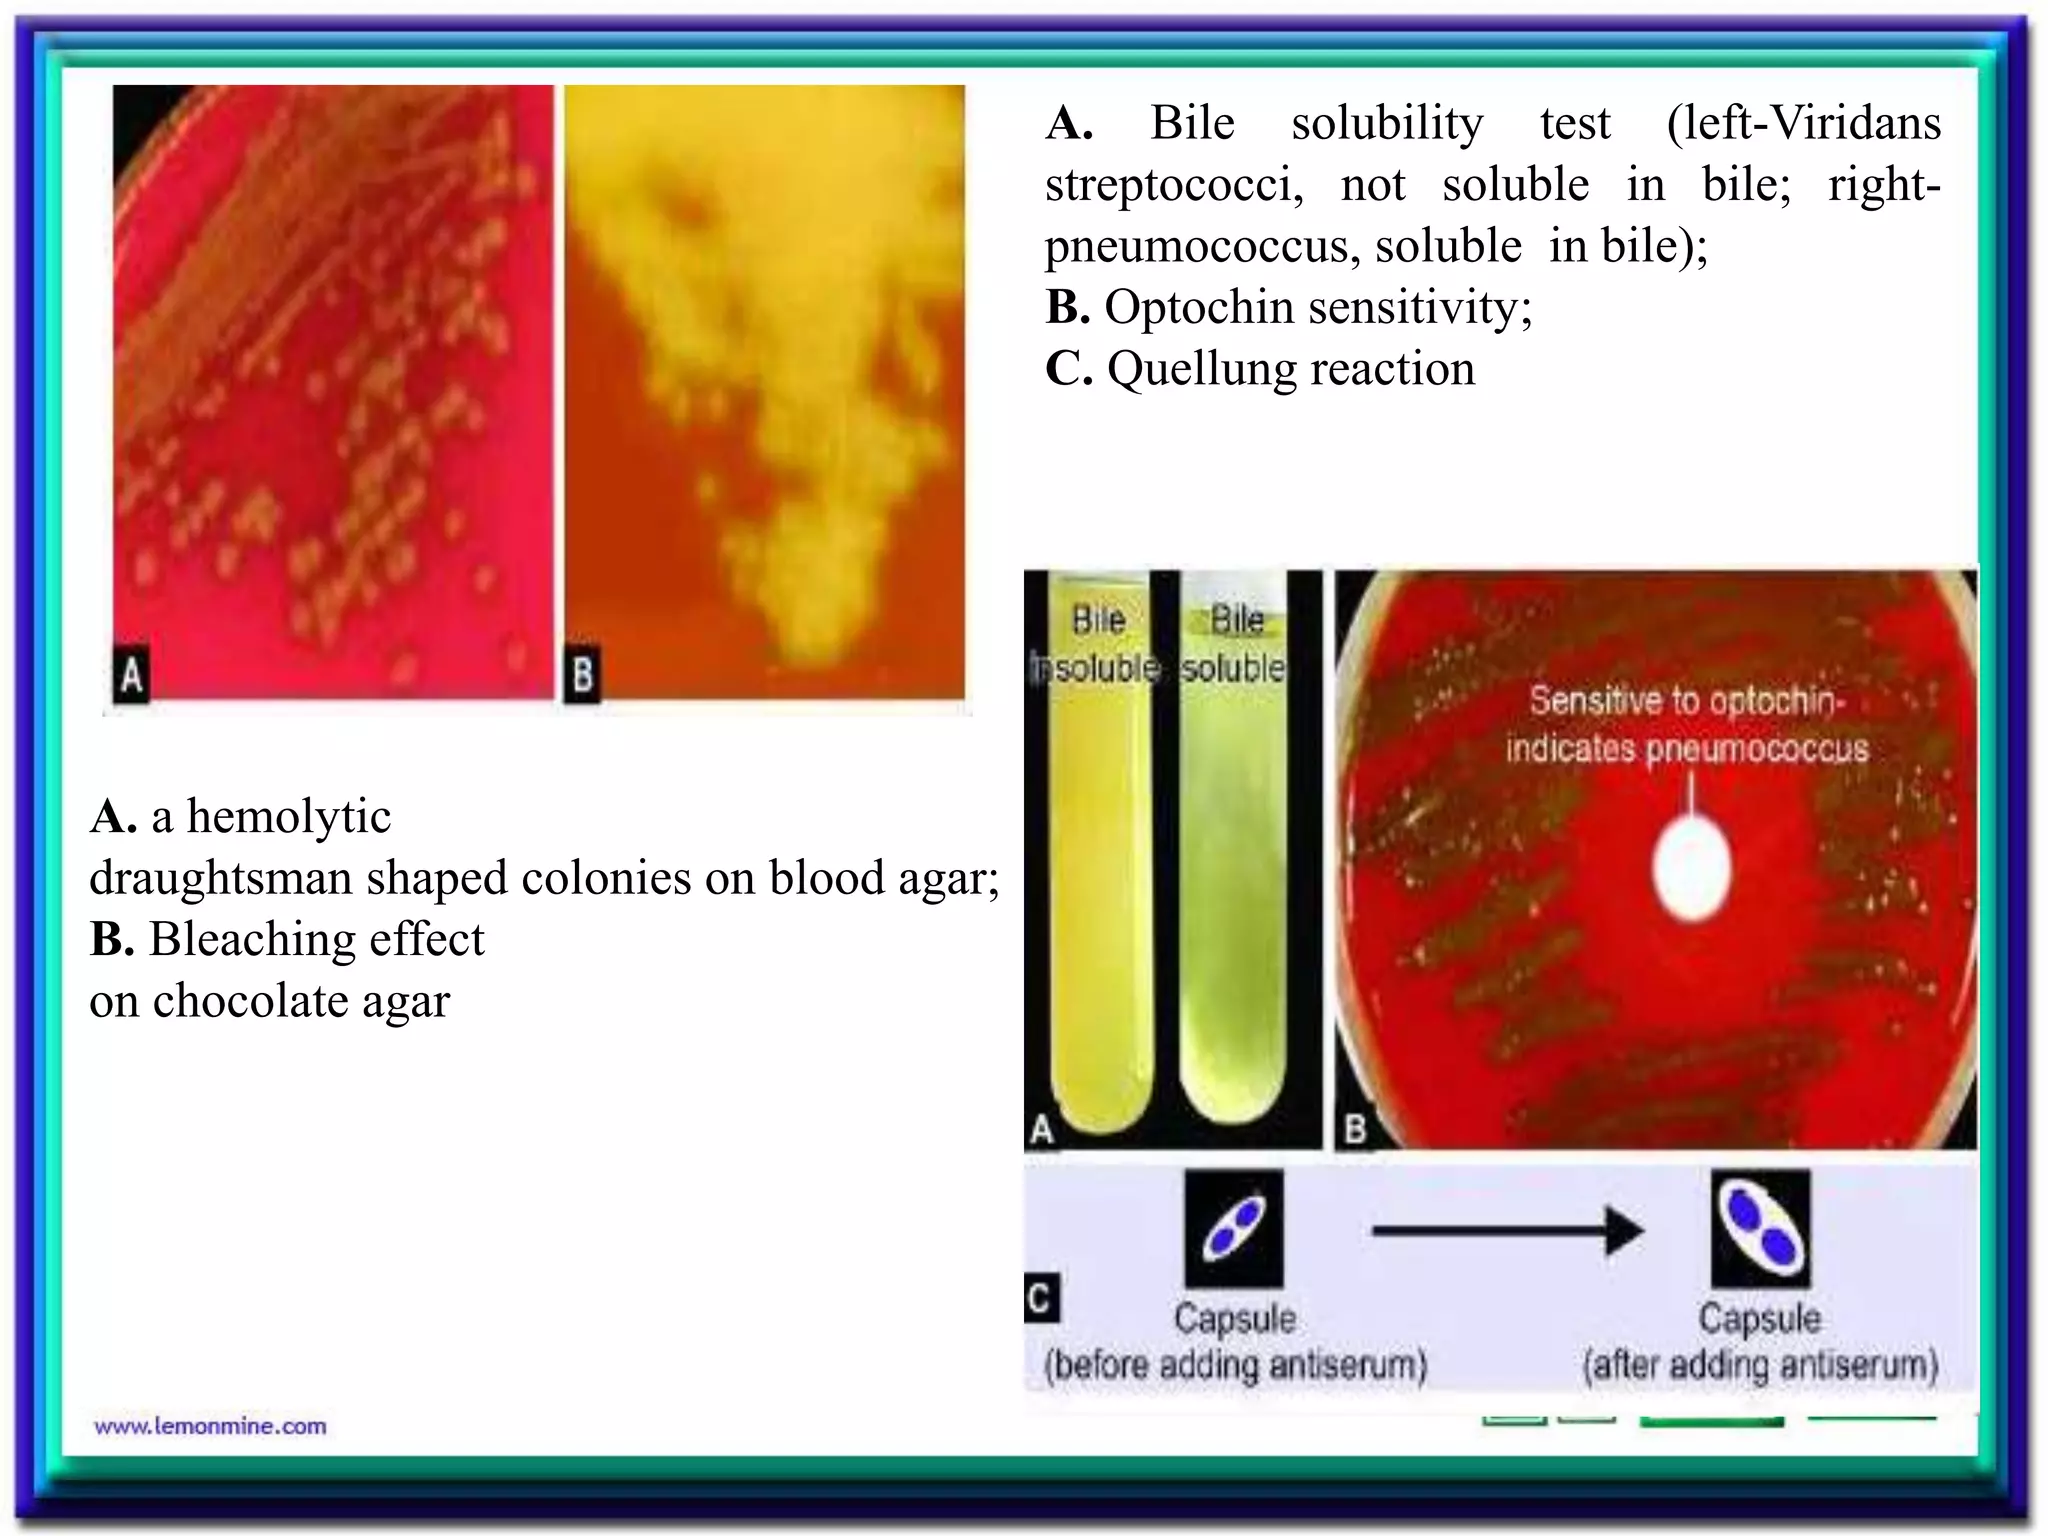
A. a hemolytic
draughtsman shaped colonies on blood agar;
B. Bleaching effect
on chocolate agar
A. Bile solubility test (left-Viridans
streptococci, not soluble in bile; right-
pneumococcus, soluble in bile);
B. Optochin sensitivity;
C. Quellung reaction

Streptococcus is a diverse genus of gram-positive bacteria that includes both commensal and pathogenic species. S. pyogenes is an important human pathogen causing pyogenic infections like pharyngitis and impetigo. It produces toxins and enzymes that contribute to its virulence. S. agalactiae can cause neonatal meningitis and infections in pregnant and immunocompromised individuals. S. pneumoniae is a leading cause of pneumonia, otitis media, and meningitis in all ages through production of a polysaccharide capsule and other virulence factors.